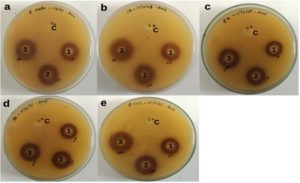

ISSN: 0973-7510
E-ISSN: 2581-690X
Postharvest microbial spoilage and inadequate packaging significantly compromise food quality during storage, necessitating the development of sustainable and functional packaging materials. A biodegradable bio-composite film (BDF) incorporating ethanolic jamun (Syzygium cumini) seed extract into a polyvinyl alcohol/polyethylene glycol (PVA/PEG) matrix was successfully developed and evaluated for sustainable food packaging applications. The jamun seed extract exhibited strong antimicrobial activity, producing inhibition zones up to 20.62 mm and 20.33 mm against food-borne bacterial and fungal pathogens. GC-MS analysis confirmed the presence of bioactive compounds with known antimicrobial and antioxidant properties, supporting the functional role of the extract in the film matrix. The developed BDF demonstrated significantly enhanced thermal stability, showing only 3% weight loss at 285 °C compared to the control film, along with a higher enthalpy change (-5 W/g), indicating improved heat resistance. Structural characterization confirmed effective incorporation of the extract, while SEM analysis revealed a rough and porous morphology that contributed to accelerated biodegradation. The film exhibited excellent UV-blocking performance, reducing UV transmittance to 15% in the UV-C region, thereby providing effective protection against photo-oxidative food degradation. Notably, the BDF showed pronounced antimicrobial activity against Staphylococcus aureus, Pseudomonas aeruginosa, and Rhizopus spp., demonstrating its potential as an active packaging material. Soil burial tests revealed rapid environmental degradation, with 92.66 ± 0.08% weight loss within 120 days, confirming its eco-friendly nature. Application studies further demonstrated that the jamun-based film effectively extended the shelf life of cherry tomatoes under both ambient and refrigerated conditions. Therefore, this study establishes jamun seed extract-based biodegradable films as a multifunctional, sustainable packaging solution with combined antimicrobial, UV-protective, thermally stable, and biodegradable properties, offering a viable alternative to conventional petroleum-based food packaging materials. This finding suggests that incorporating jamun-based bio-composite films could be a strong, sustainable bio-composite for food packaging applications.
Syzygium cumini, Bio-composite Film, Polyvinyl Alcohol (PVA), Polyethylene Glycol (PEG), Antimicrobial Activity, Packaging, Shelf Life, SDG-12
Environmental and sustainable challenges in the food packaging industry have significantly increased, as it is traditionally reliant on petroleum-based polymers and faces significant environmental challenges. Plastics, derived from fossil fuels, cause severe ecological concerns, since plastics are indispensable to modern life for various applications ranging from packaging to other diverse sectors. Predominantly used for packaging in the food sector are conventional plastics, which contribute substantially to environmental pollution, leading to the generation of biodegradable waste. The terrestrial and Aquatic systems are contaminated by Municipal solid waste, from Plastics, which make up a large portion of total waste, threatening biodiversity and food chains. Despite their advantageous properties, like flexibility and excellent barrier effectiveness, petroleum-based plastics are not biodegradable and cause serious environmental risks for landfills and the ocean.1,2 Consequently, there is an urgent global requirement to develop eco-friendly alternatives that maintain similar or superior performance characteristics compared to conventional packaging. The adoption of post-consumer recycled plastics and alternatives that are biodegradable, i.e. biodegradable polymers and biobased composites, can alleviate these concerns.3,4
The biodegradable ones provide us with an appropriate and viable alternative, which ends life in soil degradation, industrial composting, and anaerobic digestion, and thus the environmental impact is reduced.4 Nonetheless, decomposition into micro- and Nanoplastics brings about environmental impact issues as well, and therefore, their promotion must be balanced.5 Microplastics (MPs) infiltrate the human environment by direct and indirect pathways, posing health risks to the public, which is directly linked to increased risk of cancer, malfunctioning of the liver, reproductive organs, and gastrointestinal disorders. These findings highlight the urgency to be addressed and analysed to mitigate the MPs contamination, their exposure, and to safeguard human health.6 Biodegradability, biocompatibility, and sustainability are major advantages of natural biopolymer films such as polysaccharides, proteins, and lipids.7 Blending biodegradable polymers with plant extracts is a novel way to improve the quality of packaging materials, as they impart antimicrobial and antioxidant properties while improving their physicochemical, mechanical, and barrier properties, extending food shelf life and durability, along with improving the quality of packaged goods.8-10 Advances in nanoscale research and the development of nanocomposites for food packaging further enhance these materials’ capabilities, offering improved pathogen detection and antimicrobial properties.11,12
While various plant extracts have been incorporated into biopolymer films in earlier studies, limited studies are available to demonstrate the potential of the jamun (Syzygium cumini) seed extract. The scalability of the biodegradable film is founded on the abundant amount of inexpensive Jamun (Syzygium cumini) seed, which is a byproduct of fruit processing and urban juice production. The use of Jamun seed extract as a natural anti-bacterial agent would help limit the use of synthetic additives, thereby reducing regulatory and formulation costs. Because of all these quality characteristics, the suggested film is an economically viable solution in packaging that would comply with the principles of the circular economy covered by Sustainable Development Goal 12, which focuses on responsible consumption and production. Therefore, this study explores jamun seed extract, which is rich in polyphenols and anthocyanins,13 to enhance film stability and antimicrobial efficacy. In a recent research study, combining Starch extracted from Jamun seed with tamarind kernel xyloglucan and incorporating it with chitosan nanoparticles has shown excellent water vapor barrier properties, improved mechanical strength, antimicrobial efficacy, and accelerated biodegradability.14 While attracting focus towards the important use of barberry pulp extracts as a functional ingredient in future foodstuffs, controlled release kinetics of anthocyanin and phenolic compounds in chewing gum formulations have been highlighted as providing greater and better efficacies in colour stability and texture than currently available plants and fruits, such as raspberry, wine, cherry, cranberry, and pine nuts in foodstuff applications.15 Polylactic acid (PLA) and polyvinyl alcohol (PVA) in a studied because of citations of a higher and better rate of colour.16,17 These movies efficiently battle the pathogens, Escherichia coli and Salmonella spp., implying that they can be used in food or pharmaceutical packaging.18 Additionally, essential oils (EOs) such as carvacrol, eugenol, and thymol, recognised for their antimicrobial efficacy and stability under thermal processing, present a natural solution for enhancing food packaging safety and shelf life.19-22
Fruit and vegetable post-harvest losses caused by water, microbial infection, and poor storage can range from 15%-50% globally reported.23 Specifically, Cherry tomatoes are rich in carotenoids and antioxidants, including vitamin C, lycopene, and polyphenols,24 and have been shown to help reduce the risk of heart disease and cancer.25 However, despite the nutritional value, cherry tomatoes are highly susceptible to postharvest pathogens, namely Rhizopus spp., Botrytis cinerea (gray mold), Alternaria alternata (black mold), Fusarium oxysporum, and Geotrichum candidum (sour rot), which significantly affect their shelf life by causing decay and spoilage, reducing the marketability and quality of tomatoes during storage and transportation.26 Because of this, the need to develop alternatives to current packaging technologies has arisen, and an attempt has been made to produce a novel jamun extract-coated biodegradable polymer to enhance the shelf life of cherry tomatoes. The main aim of this study is to develop a novel biodegradable film based on jamun seed extract specifically designed for food packaging applications. The experiment entails the assessment of the antimicrobial efficacy of the seed extract and phytochemical content of the plant extracts by means of Gas Chromatography-Mass Spectrometry (GC-MS). To develop a biodegradable film using plant-derived resources and biodegradable polymers. Evaluate the developed film’s thermal and structural characteristics using Thermogravimetric Analysis (TGA), Differential Scanning Calorimetry (DSC), UV-Diffuse Reflectance Spectroscopy (UV-DRS), X-ray Diffraction (XRD), Scanning Electron Microscopy (SEM), and Fourier Transform Infrared Spectroscopy (FTIR). To determine the biodegradability of the packaging material through appropriate testing methods. Finally, to determine the practical use of the films in food products and assess their sensory properties and shelf-life characteristics.
Materials
The cherry tomatoes that had not been damaged physically were bought at the Koyambedu market in Tamil Nadu, India. Analytical grade chemicals were purchased from Sigma Aldrich Chemicals Private Limited, Bangalore, Karnataka, India.
Extraction of Jamun seed powder using the solvent method
Jamun seed powder extraction was done as described in Das et al.27 and Kaur & Aggarwal.28 In brief, 10 g of Jamun seeds were collected, dried, ground into a fine powder, and extracted using ethanol. The mixture was stirred at room temperature or slightly elevated temperatures. After filtration, the filtrate was concentrated using rotary evaporation to obtain an extract rich in bioactive compounds.
Antimicrobial activity of Jamun seed extract
An antimicrobial assay for Jamun seed extract was performed using the agar well diffusion method.29 In brief, the test organisms were inoculated in nutrient broth and incubated overnight at 37 °C to adjust the turbidity to 0.5 McFarland standards, giving a final inoculum of 1.5 × 108 CFU/ml. Mueller-Hinton Agar (MHA) plates were punctured with four wells using sterile replicas, and sterile test organisms were inoculated on them. Each well was filled with varying concentrations of 100, 150, and 250 µg/ml samples, with a positive control as streptomycin 25 mcg and a negative/solvent control as DMSO, respectively. The plate was allowed to diffuse for about 30 minutes at room temperature and incubated for 18-24 hours at 37 °C. After incubation, plates were observed for the formation of a clear zone around each well, which corresponds to the antimicrobial activity of the tested samples. The zone of inhibition (ZOI) was observed and measured in mm.30,31
GC-MS analysis of bioactive compounds
GC-MS analysis was performed using a Shimadzu Ultra QP 2010 to identify components in the jamun seed ethanolic extract. The sample (2 ml/minute flow rate) was injected into a GC system with a capillary column, and components were separated based on volatility and affinity. The mass spectrometer identified compounds by comparing mass spectra with NIST databases.32,33
Preparation of Biodegradable Film Using PVA/PEG/Jamun Seed Extract
Biodegradable Films (PVA/PEG/JSE BDFs) were produced using polyvinyl alcohol (PVA), polyethylene glycol (PEG), and jamun seed extract (JSE) by the gel casting method.34 In brief, a PVA matrix was prepared by dissolving 2.0 g of PVA in 50 mL of distilled water with continuous magnetic stirring at 500 rpm at 90 ± 2 °C for 45 min to achieve the entire dissolution. PEG plasticizer was made by dissolving 2.0 mL of liquid PEG in 50 mL of distilled water at 25 ± 1 °C with 200 rpm mechanical agitation for 30 minutes. A 1:1 volume ratio of PVA and PEG solutions was subjected to shear mixing for 45 minutes at 3000 rpm, ensuring uniform distribution of the combined polymer matrix. An aqueous dispersion was made by dissolving jamun seed extract (10% w/w total solids) with the polymer-plasticizer blend and homogenized vigorously for 20 minutes. The resulting solution was then transferred to a 90 mm diameter Petri dish. The films were made air-dried at 25 ± 1 °C and 55 ± 5% relative humidity for 48 hours.
Characterization of PVA/PEG/JSE film
SEM
Carl Zeiss Gemini-300 High-Resolution Scanning Electron Microscope is used to analyse the morphological features of PVA/PEG/JSE BDF and the control film. Mounted on aluminium stubs with conductive carbon tape sprayed with chromium under vacuum pressure, the film samples are subjected to an accelerating voltage of 10 kV during the examination.35
UV-vis spectroscopy
A German-made Analytik Jena UV-visible/DRS spectrophotometer (SPECORD 210 PLUS, Jena, Germany) was employed to measure the UV-visible spectra of the PVA/PEG/JSE BDF. The transparency of the sample was evaluated within the 200-900 nm wavelength range.
XRD
The X-ray diffraction (XRD) analysis of PVA/PEG/JSE BDF and control samples was carried out using CuKα radiation (λ = 1.54 nm) with an Ultima IV advanced X-ray diffractometer, made by Rigaku Japan. The measurements were performed at a voltage of 40 kV and a current of 40 mA. The samples underwent a Bragg angle scan at 2θ, spanning a range from 10-90 °C, with a programmed count step size. The analysis included observing the strength of the diffraction peaks, with a focus on identifying the maximum peak intensity.35
FTIR
FTIR- ATR sample spectra of PVA/PEG/JSE BDF and control film were recorded in spectroscopy (Thermo Fisher Scientific USA, Nicolet iS10), ranging from 4000 cm-1 to 500 cm-1.35
TGA
The thermal stability of the film was assessed using an SDT Q600 thermogravimetric analyser (TGA) in Waltham, Massachusetts, USA. The film samples were subjected to heating from 50-800 °C at a rate of 10 °C per minute under a nitrogen atmosphere flowing at 140 mL/min. This process was conducted to determine the decomposition peak values and transition temperatures.35
DSC
The DSC Q20 model instrument was used to analyse DSC experiments in a nitrogen atmosphere at temperatures ranging from 30-200 °C. The heating and cooling rates were 10 °C/min and 100 °C/min from 30-200 °C and 200-30 °C, respectively, to eradicate the influence of thermal history. The thermal history was removed, and the DSC profiles of the film samples were obtained at a heating rate of 10 °C/min from 30 to 200 °C.35
Antimicrobial activities
JEE was tested with the agar diffusion method. In brief, each well in Muller-Hinton agar was filled with varying concentrations of 100, 150, and 250 µg/ml samples of 423 mg JEE concentration. Escherichia coli, Pseudomonas aeruginosa, Staphylococcus aureus, Enterococcus faecalis, and Candida albicans were used.
For the disc diffusion study, PVA/PEG/JSE BDF was cut into uniform discs (diameter: 6 mm) and used after UV sterilization. Staphylococcus aureus, Pseudomonas aeruginosa, and Rhizopus species were used. Nutrient agar and potato dextrose agar were utilized for the cultivation of bacterial strains and fungal testing.
For both studies, the plates were incubated at 37 ± 2 °C for 24 hours for the bacterial culture and at 25 ± 2 °C for 48 hours for the fungal culture. The zones of inhibition around the film discs were measured in mm.36,37
Biodegradability test of film
A soil burial degradation test assessed film biodegradability. Film fragments (2×7 cm) were placed in natural soil at a depth of 10 cm (23 ± 2 °C, 50 ± 5% RH). At periodic intervals of 30 days, samples were collected, rinsed often with distilled water, and dried in a 50 °C oven for 24 hours.35 The percentage of weight loss for the deteriorating films was monitored and recorded.
Shelf-life studies of cherry tomatoes
Cherry tomatoes were packed with control and PVA/PEG/JSE BDF films and stored at room temperature (27 ± 2 °C, 65% humidity) and refrigerated conditions (10 ± 0.5 °C). The groupings were as follows: (i) Cherry tomatoes packed with control film and stored at room temperature (G1); (ii) Cherry tomatoes packed with control film and stored in refrigerated condition (G2); (iii) Cherry tomatoes packed with PVA/PEG/JSE BDF and stored at room temperature (G3); (iv) Cherry tomatoes packed with PVA/PEG/JSE BDF and stored at refrigerated condition (G4). The overall acceptance was evaluated by 20 panellists using a hedonic scale (0-9 points).28
Statistical analysis
All experiments were conducted in triplicate, and one-way analysis of variance (ANOVA) was conducted to compare the mean and standard deviation values across different groups. The significance level was set at p < 0.05.
Jamun seed extract and PVA/PEG/JSE Biodegradable film
Freshly prepared jamun seeds were extracted with ethanol and tested for their antimicrobial potential, as well as screened for the presence of valuable phytochemical constituents. The extraction process yielded 423 mg of crude Jamun seed ethanolic extract, corresponding to a 4.23% yield based on dry weight. Further, Jamun seed ethanolic extract (JEE) was incorporated into the PVA/PEG film-forming solution at a concentration of 3.38 mg mL–¹. The resulting solution was cast onto a levelled glass plate and dried under controlled conditions. The prepared biodegradable films exhibited an average thickness of 0.3 cm (3000 µm) (Figure 1).
Figure 1. The macroscopic appearance of bio-composite films made of biodegradable polymers made of polyvinyl alcohol/polyethylene glycol (PVA/PEG). The film used is in the left column with Jamun (Syzygium cumini) seed ethanolic extract (JEE) whereas the other column indicates the control microfilm without JEE
The surface morphology of the control film and PVA/PEG/JSE BDF differs significantly according to SEM analysis (Figure 2). The PVA/PEG SEM images show a relatively smooth and homogeneous surface with some slight imperfections, indicating a well-mixed polymer blend, similar to the earlier polymer blend study.38 The surface morphology of PVA/PEG films reflects the homogeneous distribution of both polymers, resulting in a coherent structure with minimum phase separation39 reported that the PVA/PEG mix had a homogeneous phase with no phase separation, indicating good miscibility of PVA and PEG. In this study, the biodegradable film (PVA/PEG/JSE BDF), which included jamun seed extract along with PVA/PEG, exhibited a rougher, porous, and more textured morphology (Figure 2a,b,c), indicating the attachment of plant compounds. This could enable and improve the swelling nature and thus increase the biodegradability of PVA/PEG/JSE BDF. These results agree with those of Bukhary et al., who developed a biodegradable film using sodium alginate, guar gum, and PVA with a porous nature, which enabled and improved the swelling property and thus increased the biodegradability.40 This altered surface is likely due to the jamun seed extract’s components influencing the film’s microstructure, with bioactive compounds potentially creating a more complex surface.13,41 In turn, this surface modification may contribute to improved interaction between the film and its environment, potentially enhancing properties such as antimicrobial activity or resistance to moisture and gases, and it directly correlates with the biodegradable mechanism due to the roughness and porosity surface area and binding.42
Antimicrobial activity of Jamun Seed Extract (JSE)
The agar well diffusion assay is used to evaluate the efficacy of the antimicrobial activity of the drug compounds and plant extracts. In this study, the antimicrobial activity of Jamun seed extract (JSE) was evaluated against bacterial and fungal pathogens using the agar well diffusion method.28,43 Table 1 and Figure 3 depict the effectiveness of JSE against Enterococcus faecalis (Figure 3a) and Staphylococcus aureus (Figure 3b), with maximum inhibitory zones of 20.62 mm and 20.33 mm for Candida albicans at 200 µg (Figure 3c), while showing moderate inhibition of 18 mm and 16 mm at 200 µg against Pseudomonas aeruginosa and Escherichia coli (Figure 3d and 3e). 1% of DMSO was used as a negative control and showed no inhibition, confirming the antibacterial efficacy of the extract in accordance with the previous study, which observed that the methanolic extract of jamun seed inhibited the activity of Bacillus subtilis, measuring an inhibition zone of 20 mm.44 The zone of inhibition varies depending on the type of strain, its structure, and cell membranes, affecting the extract’s permeability.33 Jamun seed extracts’ antimicrobial activity results show potential antimicrobial agent against hazardous pathogens and can be used for various medicinal applications. These results are corroborated by the early study conducted, which reported the antimicrobial potential of jamun seed extract using ethanol against 10 bacterial strains and 5 fungal strains.29
Table (1):
Antimicrobial Activity of Jamun Seed Extract
| Organism | Zone of Inhibition (in mm) | ||
|---|---|---|---|
| 100 µg | 150 µg | 200 µg | |
| Enterococcus faecalis | 14.33 ± 0.89ab | 17.67 ± 0.88ab | 20.62 ± 0.88c |
| S. aureus | 14.67 ± 0.88ab | 18.00 ± 0.56ab | 20.62 ± 0.88b |
| C. albicans | 15.67 ± 0.89c | 19.68 ± 0.71c | 20.33 ± 0.88bc |
| P. aeruginosa | 12.33 ± 0.88ab | 15.67 ± 0.89b | 18.00 ± 0.57ab |
| E. coli | 10.00 ± 0.58a | 12.67 ± 0.58a | 16.00 ± 0.57a |
Note: Values were expressed as mean ± standard deviation and were calculated by the zone of inhibition. Small letters (a, ab, c) within a column show significant differences as assessed by one-way analysis of variance (ANOVA) significance at P < 0.05
Figure 3. Antimicrobial activity of Jamun seed Extract (a) Enterococcus faecalis, (b) Staphylococcus aureus, (c) Candida albicans, (d) Pseudomonas aeruginosa, (e), Escherichia coli
1). 100 µg/ml; 2). 150 µg/ml; 3). 250 µg/ml; C – Negative Control
GC-MS analysis of Jamun Seed Extract
GC-MS chromatogram analysis of JSE from ethanol (Figure 4) revealed the presence of 48 compounds (Table 2), indicating a wide variety of phytochemicals, including carotenoids, alkaloids, flavonoids, phenols, terpenoids, steroids, carbohydrates, proteins, and amino acids.45 Among the 48 components, the most significant phytocomponents found in abundance were Ethyl trans-2-decanoate, lanosta-8,24-dien-3-ol, (3. Beta.)-Butyl 9-decanoate, Hexadecanoic acid, and Octadecanoic acid ethyl ester, corresponding to 20.91%, 9.30%, 7.35%, 6.25%, and 4.30%, respectively. The least abundant component present in the extract was Ethyl alpha.-d-glucopyranoside (0.29%). The most prevalent key components of JSE reported by other researchers and noted in the current study include Tetradecanoic acid, hexadecenoic acid, cyclooctasiloxane, and octadecanoic acid, which exhibit anti-inflammatory, antidiabetic, antiviral, antihistamine, spermatogenic, antimicrobial, antioxidant, hypocholesterolemic, nematicide, cardioprotective, therapeutic, and potential anticancer properties.46-48
Table (2):
GC-MS analysis of ethanolic extracts of jamun seed
Peak |
Retention Time |
Area |
Area % |
Name |
Molecular weight |
Molecular Formula |
|---|---|---|---|---|---|---|
1 |
6.643 |
200790 |
0.52 |
Dodecane |
170 |
C12H26 |
2 |
7.132 |
183963 |
0.48 |
Benzaldehyde, 2,4-Dimethyl |
134 |
C9H10O |
3 |
10.360 |
126651 |
0.33 |
Alpha.-L-Galactopyranoside, Methyl 6-Deoxy |
178 |
C7H14O5 |
4 |
11.915 |
1370225 |
3.55 |
Tetradecane |
198 |
C14H30 |
5 |
11.989 |
1295354 |
3.36 |
Trans-2-Decenoic Acid |
170 |
C10H18O2 |
6 |
12.080 |
584439 |
1.52 |
Ethenol, 2-Ethoxy-, Acetate |
130 |
C6H10O3 |
7 |
13.204 |
8064750 |
20.91 |
Ethyl Trans-2-4′,5,6,7,8-Pentametho- xyflavone |
198 |
C12H22O2 |
8 |
14.695 |
177272 |
0.46 |
Phenol, 2,4-Bis(1,1-Dimethylethyl |
206 |
C14H22O |
9 |
15.137 |
689425 |
1.79 |
3-Hydroxydecanoic Acid |
188 |
C10H20O3 |
10 |
15.343 |
1529417 |
3.97 |
Ethyl 3-Hydroxytridecanoate |
258 |
C15H30O3 |
11 |
15.672 |
472740 |
1.23 |
10-Undecenoic Acid, Ethyl Ester |
212 |
C13H24O2 |
12 |
16.228 |
113530 |
0.29 |
Ethyl .Alpha.-D-Glucopyranoside |
208 |
C8H16O6 |
13 |
16.576 |
178031 |
0.46 |
9-Tetradecenal, (Z)- |
210 |
C14H26O |
14 |
16.858 |
282548 |
0.73 |
Trans-2-Dodecenoic Acid |
198 |
C12H22O2 |
15 |
16.916 |
141025 |
0.37 |
Hexadecane |
226 |
C16H34 |
16 |
17.245 |
309732 |
0.80 |
Ethyl. Alpha.-D-Glucopyranoside |
208 |
C8H16O6 |
17 |
17.445 |
274289 |
0.71 |
6-Deoxyhexose |
164 |
C6H12O5 |
18 |
17.561 |
865604 |
2.24 |
Ethyl Decyne Carbonate |
210 |
C13H22O2 |
19 |
17.907 |
1129933 |
2.93 |
Ethyl Non-2-Enoate |
184 |
C11H20O2 |
20 |
19.274 |
172283 |
0.45 |
Ethyl 3-Hydroxyoctadecanoate |
328 |
C20H40O3 |
21 |
19.721 |
138858 |
0.36 |
Ethyl 3-Hydroxydodecanoate |
244 |
C14H28O3 |
22 |
20.799 |
116440 |
0.30 |
Tetradecanoic Acid, Ethyl Ester |
256 |
C16H32O2 |
23 |
22.789 |
625900 |
1.62 |
1,2-Benzenedicarboxylic Acid, Bis |
278 |
C16H22O4 |
24 |
23.622 |
409890 |
1.06 |
1,4-Dibutyl Benzene-1,4-Dicarboxylate |
278 |
C6H2204 |
25 |
23.728 |
1093535 |
2.84 |
N-Hexadecanoic Acid |
256 |
C16H32O2 |
26 |
23.929 |
255102 |
0.66 |
Phthalic Acid, Butyl Tridecyl Ester |
404 |
C25H40O4 |
27 |
24.293 |
2409168 |
6.25 |
Hexadecanoic Acid, Ethyl Ester |
284 |
C18H36O2 |
28 |
25.186 |
128624 |
0.33 |
1-Butyl 2-(8-Methylnonyl) Phthal |
362 |
C22H34O4 |
29 |
26.346 |
232939 |
0.60 |
Heptatriacontane |
520 |
C37H76 |
30 |
26.917 |
337428 |
0.87 |
2-Aminoethanethiol Hydrogen Su |
157 |
C2H7NO3S2 |
31 |
27.009 |
520771 |
1.35 |
Ethyl Oleate |
310 |
C20H38O2 |
32 |
27.109 |
145252 |
0.38 |
(E)-9-Octadecenoic Acid Ethyl Ester |
310 |
C20H38O2 |
33 |
27.423 |
1659138 |
4.30 |
(E)-9-Octadecenoic Acid Ethyl Ester/Stearic Acid |
284 |
C18H36O2 |
34 |
27.965 |
162880 |
0.42 |
0.42 Cyclooctancarbonsaeure, 4-Met |
198 |
C12H2202 |
35 |
28.683 |
306353 |
0.79 |
Ethyl 13-Docosenoate(Ethyl Erucate) |
366 |
C24H46O2 |
36 |
29.143 |
543345 |
1.41 |
Ethyl 10-[(8,19-Dioxo-3,6,9,20-Tetrao |
574 |
C30H54O10 |
37 |
29.271 |
470439 |
1.22 |
Pimelic Acid, Ethyl Hexadecyl Ester |
412 |
C25H48O4 |
38 |
29.422 |
323286 |
0.84 |
Octadecane |
254 |
C18H32 |
39 |
30.200 |
706178 |
1.83 |
Hexanedioic Acid, Bis(2-Ethylhexyl) Ester |
370 |
C22H24O4 |
40 |
30.504 |
261256 |
0.68 |
Ethyl 10-[(8,19-Dioxo-3,6,9,20-Tetrao |
574 |
C30H54O10 |
41 |
30.690 |
1475508 |
3.83 |
Butyl 9-Decenoate |
226 |
C14H22O2 |
42 |
31.813 |
2833516 |
7.35 |
Butyl 9-Decenoate |
198 |
C12H202 |
43 |
31.910 |
125651 |
0.33 |
Undecanoic Acid, 4,8-Dimethyl-10- |
242 |
C14H26O3 |
44 |
33.035 |
265182 |
0.69 |
Bis(11-Ethoxy-11-Oxoundecyl) Seb |
626 |
C36H66O8 |
45 |
33.855 |
3585306 |
9.30 |
Lanosta-8,24-Dien-3-Ol |
426 |
C30H50O |
46 |
34.041 |
239946 |
0.62 |
Dithiocarbamate, S-Methyl-, N-[1-(2-Oxocyclo |
285 |
C14H23NOS2 |
47 |
34.265 |
134909 |
0.35 |
Pentadecanoic Acid, 13-Oxo-, Ethyl Ester |
284 |
C17H32O3 |
48 |
35.827 |
895057 |
2.32 |
4′,5,6,7,8-Pentamethoxyflavone |
372 |
C20H20O7 |
Characteristic studies of PVA/PEG/JSE BDF
FT-IR analysis
The FTIR spectra are the most used technique to identify the functional group and its interactions. Figure 5 displays characteristic peaks, which include O-H stretching vibrations around 3200-3550 cm-1, C-H stretching vibrations near 2800-3000 cm-1, and C=O stretching around 1700 cm-1 corresponding to the functional groups in PVA and PEG, making the polymer stronger during the process.49 Incorporating jamun extract into the PVA/PEG matrix altered the FTIR spectra significantly. The PVA/PEG/JSE BDF shows additional peaks or shifts in existing peaks, reflecting the presence of bioactive compounds from the extract. Notable changes included enhanced O-H stretching vibrations due to the phenolic compounds and new peaks around 1500-1600 cm1, corresponding to aromatic C=C stretching, indicating the presence of flavonoids. These changes in peak positions, indicative of the plasticizing effect of PEG on PVA, their chemical behaviours, and the formation of hydrogen bonds between polymer chains are ascertained through FTIR analysis.50 Shifts in FTIR peak positions and changes in intensity of peaks respectively testify to shifts in the interactions among molecular structures, the mobility of polymer chain and crystallisation, both of which subsequently affect the properties of the film at large, such as mechanical flexibility or thermal resistance.51-53
TGA Analysis
The Thermogravimetric Analysis (TGA) of PVA/PEG/JSE BDF highlights the significant variation in the mass of the material in controlled atmosphere as the temperature or time is a function and reflects on their stability against thermal decomposition of the material. The control film exhibited the highest weight loss of 10 percent at 273 °C using a combination of PVA and PEG and PVA/PEG/JSE BDF had 3 percent weight loss at 285 oC and therefore, a much lower weight loss than that of the control. This implies improved thermal resistance and significant decrease in weight loss of jamun-based PVA/PEG/JSE BDF and hence they are more appropriate to pack where thermal stability is majorly considered.54 In Figure 6, TGA curves of PVA/PEG films typically exhibit distinct degradation stages corresponding to the thermal decomposition of PVA and PEG components. The plant extracts used in the integration may alter these disintegration temperatures through either displacing them by the polymer and plant interaction or by incorporating extra stages of the decomposition process of the parts of the extracts.55 In this study, the developed PVA/PEG/JSE BDF is believed to form hydrogen bonds with the polymer chains due to the phenolic compounds present in jamun extract, increasing resistance to thermal degradation and stability of the film.
DTG analysis
Differential Thermogravimetric (DTG) analysis additionally provides further information on the pattern of degradation of biodegradable films. The DTG analysis of the control film (PVA/PEG) exhibited a weight reduction of 1%, while PVA/PEG/JSE BDF exhibited a smaller weight reduction of 0.8%. This fall in decreasing weight reduction for the PVA/PEG/JSE BDF strengthens the improved thermal stability, as shown in Figure 7. DTG analysis also showed shifts in peak positions or differences in decomposition rates, indicating variations in polymer interactions and thermal stability as changes in PEG content. The study was further reinforced by prior study in forming an active packaging material utilizing a composite blend of polylactic acid (PLA), poly ו-capro lactone (PCL), and polyethylene glycol (PEG), chitosan and final incorporation of antibacterial and antioxidant agents such as Syzygium Cumini Seed Extract (SCSE) which was used to enhance thermal interactions and resulted to better mechanical strength as well as prolonged stability.56,57 This material might be considered to be promising in the field of packaging that exhibits both eco-friendly and heat-resistant properties.
DSC analysis
Differential Scanning Calorimetry (DSC) analysis of PVA/PEG/JSE BDF and control film reveals a lot about the thermal stability of the sample and their properties. A control film (PVA/PEG) has an enthalpy change of -4.2 W/g, and the PVA/PEG/JSE BDF had a low enthalpy change of slightly higher, -5 W/g. This difference means that the ability of the jamun to enhance the thermal stability of the film is depicted in Figure 8. Nonetheless, it is important to realise that particular plant extracts may lower thermal stability due to existence of low molecular weight substances, which may amplify degradation procedure at low temperatures.58 Thermal modifications are significant in the examination of rigid and elasticity of the composite film, so it is significant in packaging and therapeutic used cases.59,60 In this study, the DSC analysis showed a broad endothermic peak at 73.15 °C for the control and 74.91 °C for the Jamun sample, probably caused by different compounds in the Jamun extract. A second endothermic peak was observed at 215.05 °C and 217.89 °C for the control and jamun samples, respectively, which could be attributed to the remaining solvent effects in film preparation. These results propose changes in the degree of crystallinity. Comparison study of DSC results of the control and PVA/PEG/JSE BDF demonstrates that the endothermic peaks have moved towards higher temperatures, showing enhanced thermal behaviour. Specifically, at 201.25 °C, the control sample absorbed 35.88 J/g of energy, while the jamun sample absorbed 43.44 J/g, showing improved thermal performance or energy-holding capacity of PVA/PEG/JSE BDF. The DSC curve shows an expansion and narrowing in the strength of peaks in the jamun samples relative to the control sample, indicating a reduction in melting enthalpy with a rise in thermal absorbance. These properties make jamun-based PVA/PEG/JSE BDF an appropriate to synthetic polymer packaging, which is strongly supported by the previous findings of Bukhary et al.,40 who described examination of a biodegradable polymer using sodium alginate, guar gum, corn starch, and gelatin. A distinct and precise melting peak typically shows a higher level of purity, though a broad and uneven curve shows the existence of impurities or multiple thermal reactions. A commonly observed coincidence that is accompanied by the loss of moisture of the compound is the existence of an endothermic spike. In some way, the thermal stability and energy dissipation properties can be potentially better in jamun sample because the first endothermic peak was at 74.91 °C with increased enthalpy of fusion, which indicates that it could be more effective in thermoregulation and supply energy to the bacterial cells as heat. This is because the first peak of an endothermic reaction was at 74.91 °C with higher enthalpy of fusion as compared to the control sample, which could be more useful in the thermoregulation process, and that could provide energy.49
The micrographs of SEM analysis indicate that the roughness of the surface and porous morphology may exert a significant effect on the barrier performance and mechanical integrity of the biodegradable film. The increased micro-porosity and roughness of the surface can potentially accelerate the diffusion of gases and water, effectively reducing barrier properties; however, this structural property can also increase the contact between the polymer matrix (PVA/PEG) and Jamun seed phytochemicals, which also increases overall performance. More importantly, thermal analyses support the thermo-stasis of the film, despite the porous morphology of the film. Differential scanning calorimetry (DSC) shows a higher enthalpy and a better thermal transition, which jointly indicate stronger intermolecular interactions and restricted mobility of the polymer chains in a partial manner due to extract integration. Thermogravimetric analysis (TGA) also shows lower weight loss and higher thermal stability, and thus confirms that the porous structure is not compromising thermal integrity. Combined with the observations above, these points suggest that even though surface roughness and porosity can mediate the permeability properties, these measures establish the enhancement of the thermal properties by DSC and TGA that testify to the sufficient structural integrity and to the applicability of the film to food-packaging purposes.
XRD analysis
The X-ray Diffraction (XRD) of PVA/PEG/JSE BDF and control (Figure 9) displayed significant differences in giving important information about their crystalline structure, phase Compositions, and crystallinity level. In the case of the control film, the XRD pattern normally displays peaks with a sharper shape, reflecting a semi-crystalline structure. The results were found to be similar to those in their study, showing that PVA/PEG and silver bio-composite blends generally possessed a semi-crystalline structure by the XRD analysis. The observed peaks in the diffraction pattern at different angles (2nd) are due to crystalline phases of both polymers.49 The observed crystal peaks in the XRD at angles of 2nd diffraction include (11.09°, 19.69°, 25.35°, 41°) that are referred to cellulose types I and IV. The same findings were reauthenticated and described by a study with Syzgium cumini (L.) Skeels powder (S. cumini powder).
The crystallinity index (CI) of the PVA/PEG/JSE BDF film was measured at 41.00%, meaning the ratio of crystallinity to amorphous constituent. This figure is very similar to that of Thiagamani et al.,49 who have reported that the CI value of jamun seed powder was 42.63% of jamun seed powder. According to these values, it is perceived that PVA/PEG/JSE BDF may be described as amorphous in its major part, and its structural features testify to this matter. The JSE-based film showed a reduced crystalline structure and amorphous nature during the casting, which was associated with a homogeneous mixture as compared to the control film. Widespread peaks of the PVA/PEG/JSE BDF indicate a more amorphous phase. On the contrary, the control samples are characterized by narrower diffraction peaks, which are typical of higher crystallinity. This permanent transformation resulted in the PVA/PEG/JSE BDF exhibiting amorphous properties, with a pliable and soft feel, and it becomes soluble in water, which was also reported by Navjot and Poonam.28 Hydrogen bonding and molecular interaction between extract molecules and polymer matrix might have contributed to it, as the effects of which could be beneficial, including high mechanical properties and possibly faster degradation rates, making it an attractive material in a sustainable packaging solution.
UV spectroscopy
UV Spectroscopy of the control and biodegradable films was recorded within the 200- 800 nm range, indicating a significant difference in the properties of absorption properties of the two films. The values of UAV (UV-visible absorption) of the control film are 47, 60, and 25, respectively, at 800, 400, and 200 nm, respectively, meaning that this film has a high transparency and less UV protection. On the other hand, PVA/PEG/JSE BDF presents lower absorption values of 45 percent at 800 nm, 40 percent at 400 nm and 15 percent at 200 nm. Figure 10 illustrates the percentage of UV-reflectance across the wavelength of interest of a material. The fact that the PVA/PEG/JSE BDF has a lower UV absorption or reduced transmittance at the UV region in the range of 200-400 nm is of particular importance since it implies that it has excellent UV shielding effects and that the range encompasses UV-B and UV-C, which are even worse and cause faster degradation of polymer materials and food products. These results are well supported by the studies reported by Annu et al., which stated that blending natural plant extract in films exhibited outstanding UV barrier properties compared to the control films by reducing the UV transmittance due to the polyphenols, benzene, and carbonyl compounds present in them.61 This shielding helps to prevent oxidation in food and further supports the advancement of food packaging industries, leading to a green and sustainable environment. Blocking more of this harmful UV radiation, the developed PVA/PEG/JSE BDF can potentially extend the shelf life and maintain the quality of products packaged within these films. UV light protection is a key property in the packaging material, and the result of this study showed that jamun-based PVA/PEG/JSE BDF displayed better properties in terms of UV spectrophotometric analysis.
Different plant extracts contain varying levels and types of UV-absorbing compounds; for instance, extracts from green tea, grape seeds, and rosemary are known for their high content of phenolic compounds and flavonoids, which are outstanding UV blockers.62,63 These research findings clearly indicate that the application of natural extracts is crucial in modifying the film to obtain a functional advantage, hence improving the food quality. Plant extracts are also used as they not only impart functional characteristics to the films but also bring into the films an aspect of sustainability, which is a crucial feature that is sought after in the current packaging solutions that are environment-friendly. It is possible to use natural food additives to enhance the quality of food and, consequently, also produce sustainable packaging material, which creates green packaging.
Antimicrobial activity of film
The agar well diffusion method was used to analyse the antimicrobial activity of the formed films over Staphylococcus aureus, Pseudomonas aeruginosa and Rhizopus spp. The idea of incorporating natural extracts in polymer composite film has also attracted areas of interest owing to the fact that such extracts could enhance the antimicrobial properties. In this aspect, addition of jamun seed extract to PVA-containing films has revealed a significant antibacterial and antifungal response. The antimicrobial activity of such films was determined by the zone of inhibition method, which is a common method that determines the antimicrobial activity. For Staphylococcus aureus, the PVA/PEG composite film (control) exhibited a zone of inhibition measuring 19.81 ± 0.28%, indicating some inherent antimicrobial activity (Figure 11a). However, incorporating jamun seed extract into the PVA/PEG matrix showed an enormous increase in the zone of inhibition (50.19 ± 0.32%), as shown in Figure 11c, suggesting the bioactive compounds in jamun seed extract, including phenolic acids, flavonoids, and tannins, for this enhanced antibacterial activity. Previous study demonstrated the antimicrobial activity of jamun seed methanol extract against E. coli and B. cereus (18.6 mm and 10 mm zones) compared to other methods of extractions.64 Likewise, the control film exhibited moderate antibacterial activity against Pseudomonas aeruginosa with a zone of inhibition of 24.07 ± 0.5% (Figure 11b), while jamun-based PVA/PEG/JSE BDF showed a larger inhibition zone of 62.22 ± 0.42% (Figure 11d). This pronounced enhancement suggests that the bioactive compounds in jamun seed extract are particularly effective in combating these bacteria. This suggests that it has the potential to prevent gram-negative bacteria and act as a natural antibacterial agent. This pronounced enhancement suggests that the bioactive compounds in jamun seed extract are particularly effective in combating these bacteria.
In addition to its antibacterial properties, the antifungal activity of the jamun seed extract-enhanced film was also significantly greater than that of the control. The control film exhibited a moderate antifungal inhibition against Rhizopus spp. with a zone of 17 ± 0.20% (Figure 11e), while the film containing jamun seed extract showed a considerable increase, measuring 35 ± 0.65% (Figure 11f). This enhanced antifungal activity is attributed to the presence of phytochemicals such as saponins, which have been identified as key antimicrobial agents reported in a study by Jagetia proved that bioactive components present in the Syzygium cumini seed extract are likely to kill fungal cells by inhibiting their growth.65 The extracts obtained from jamun seeds using water and methanol demonstrated antifungal properties against various dermatophytic fungi, including Candida albicans, Trichophyton rubrum, Trichophyton mentagrophytes, Microsporum gypseum, and Aspergillus niger.66 In another study by Kumar et al. confirmed that the jamun seed extract possess a very strong anti-bacterial and antifungal properties, done with the methanolic extract rather from other method of extraction, it highlights a significant activity against for both Gram-positive and Gram-negative bacteria as well as the fungal species, the presence of bioactive component make them a strong antimicrobial agent by making them a natural inhibitor.67 These findings reinforce the potential of jamun seed extract as a natural antimicrobial agent for applications in polymer composite films.
Figure 11. Antimicrobial activity of PVA/PEG/JSE BDF
(a) Control – Staphylococcus aureus (c) Test – Staphylococcus aureus; (b) Control – Pseudomonas aeruginosa (d) Test – Pseudomonas aeruginosa; (e) Control – Rhizopus spp. (f) Test – Rhizopus spp.
Biodegradability (soil burial) test of film
The burial degradation research of soils is also important in assessing the environmental sustainability of the biodegradable materials. The polymer may have the natural extract demonstrating a high ability to reduce the time for biodegrading the polymer. In this study, the weight loss percentage of the films was monitored at 30 day intervals over a total period of 120 days. The obtained results suggest that the bioactive composite film (PVA/PEG/JSE BDF) had a much higher degradation rate in contrast with the control film. As Figure 12 demonstrates, the weight loss experienced by the PVA/PEG/JSE BDF was 92.66 ± 0.08 percent as compared to the weight loss experienced by the control film, which was 74.66 ± 0.57 percent by the end of the study period. This increased biodegradability has been attributed to the fact that jamun seed extract has been integrated, which is crucial in increasing the rate of degradation. The improved degradation rate of the PVA/PEG/JSE BDF may be by the presence of bioactive compounds in the jamun seed extract, such as polyphenols, flavonoids, and tannins, which enhance moisture absorption and promote microbial colonization, according to Mousavi et al., polymer incorporated with natural plant extract can exhibit upgraded biodegradability due to microbial activity and water absorption rate, making them a green packaging solution.37 These Bio compounds could ease the breakdown of the polymer matrix by increasing its hydrophilicity and biodegradability, which involves microbial breakdown due to its complexity and promotes sustainable biodegrading, thereby allowing soil microbes to efficiently degrade the material. Another reason for the enhanced degradation of the PVA/PEG/JSE BDF could be its structural modification due to the incorporation of natural extracts. Riaz et al. suggested that the addition of natural extract to the polymer enhances the structural modifications, by polymer interactions, increasing the thickness and reducing the porosity, and helps in improving the barrier properties, making the film a more effective and sustainable packaging material.59 The polymer matrix containing jamun seed extract may exhibit increased porosity or altered surface morphology, making it more susceptible to microbial attack. These results indicate the possibility of using jamun-extract-coated composite as a promising candidate for developing biodegradable packaging material, as reported by Giacondino et al., who evaluated extending the shelf life of cherry tomatoes using a gel based on guar gum composite enriched with lemon pomace extract.60
The migration of bioactive elements to the biodegradable film is an important factor that determines the safety of food-contact and the antimicrobial activity. It has been expected that phenolic-rich phytochemical isolates of the Jamun seed extract, such as flavonoids, fatty-acid derivatives, and aromatic esters, can be minimally influenced on the antimicrobial potential at surface levels and safely within the accepted safety limits. These group members are generally known to have antibacterial effects in terms of disrupting the cell membranes of microbes, making them more permeable and taking over with enzymatic functions, thus leading to leakage of intracellular contents as well as metabolic suppression. In relation to fungal pathogens, the phenolic agents have been reported to cause cell-wall damage, mitochondrial destruction, as well as blocking of ergosterol synthesis and, as a result, hampering reproductive processes of spores and hypha growth.46-48
Shelf-life studies of cherry tomatoes
The preservation efficacy of the Jamun seed extract film on cherry tomatoes was evaluated by assessing their shelf life under different temperature storage conditions (Figure 13). Cherry tomatoes wrapped in the PVA/PEG/JSE BDF containing jamun seed extract and stored at room temperature (RT) exhibited a significantly prolonged shelf life up to six days. The antimicrobial properties of the extract might effectively inhibit microbial growth, reduce spoilage and preserve the fruit’s freshness which was confirmed by visual and sensory analysis (G3) (Figure 14). In contrast, fresh cherry tomatoes wrapped in the control film and stored at room temperature exhibited the shortest shelf life, with rapid spoilage due to the absence of antimicrobial protection and favourable conditions for microbial growth. This group (G1) recorded the lowest overall sensory rating. Similarly, tomatoes stored in refrigeration but wrapped in a control film without jamun extract (G2) had a shorter shelf life than those wrapped in a jamun extract-infused film, by extending the shelf-life to twelve days maximum under refrigeration (G4), demonstrating the added protective benefits of bioactive packaging, while the other samples were found to be less than the Jamun extract-infused film. The quality attributes, including texture and aroma, were well-maintained in the PVA/PEG/JSE BDF group until the final day of storage.
Figure 13. Shelf-life analysis of PVA/PEG/JSE BDF at different temperature conditions (PVA/PEG/JSE BDF: Biodegradable, RT – Room Temperature)
Figure 14. The sensory parameters of the stored cherry tomatoes were rated on the final day of storage, where colour, aroma, texture, and overall acceptance were recorded for all four groups (G1, G2, G3, G4)
The sensory results confirm the potential of bio-composite film developed from jamun seed extract as a natural preservation material, specifically for extending the shelf life of cherry tomatoes under both ambient temperature and refrigerated conditions. The bioactive ingredients added to the packaging films lead to the preservation of the sensory and nutritional integrity of fresh fruits and vegetables, and thus, a sustainable food preservation alternative to artificial preservatives, which would reduce the issue of food waste.
A number of studies have revealed the effectiveness of bioactive packaging in terms of the shelf life of fruits and vegetables. As an example, considerable intraoperative decrease in microbial proliferation and postponed ripening were witnessed in tomatoes covered with chitosan-based films laced with oregano essential oil, and lengthening the shelf life of tomatoes to a maximum of 14 days.68 In a similar study, it was noted that polyvinyl alcohol (PVA) films can preserve the firmness, color, and sensory quality of cherry tomatoes up to 14 days, indicating the effectiveness of bioactive packaging in the preservation of tomatoes postharvest.69,70
The outcome from the shelf-life and sensory studies indicates that the integration of jamun seed extract into biodegradable films significantly improves the storage stability of perishable foods. The Cherry tomatoes encased in the PVA/PEG/JSE BDF recognize the possibility it has to become an alternative to the normal use of plastic packaging, as it will increase its shelf life, which is 12 days long. The findings support the usefulness of bioactive plant-based films in their functional and therapeutic applications, thus explaining their promising role in food spoilage reduction and minimizing the use of plastic in food packaging.
The present study demonstrates the successful development of a multifunctional biodegradable bio-composite film incorporating jamun (Syzygium cumini) seed extract within a PVA/PEG matrix for active food packaging applications. The integration of plant-derived bioactive compounds imparted enhanced antimicrobial efficacy, UV-capability, thermal stability, and rapid biodegradability, collectively addressing key limitations of conventional packaging materials. Importantly, the practical effectiveness of the developed film was validated through shelf-life studies on cherry tomatoes, where it significantly delayed microbial spoilage and preserved product quality under storage conditions. The use of jamun seed extract, an underutilized agro-industrial byproduct, further highlights the environmental and economic advantages of this approach by promoting waste valorization and reducing reliance on synthetic additives. The combined functional performance and eco-Friendly degradation profile position this bio-composite film as a promising alternative to petroleum-based plastics for fresh produce packaging. These study findings can be observed in line with the Sustainable Development Goals (SDGs) 12 and have more ambitious approaches to minimize plastic waste and to enforce a sustainable system of packaging. Future studies should focus on large-scale processing, mechanical property optimization, migration and safety assessments, and regulatory compliance to facilitate industrial translation. In summary, this work provides a sustainable and scalable framework for the development of plant extract based biodegradable packaging materials with significant potential for commercial food preservation applications.
ACKNOWLEDGMENTS
The authors are grateful to the Faculty of Bioengineering, Sathyabama Institute of Science and Technology, Chennai, Department of Food Technology, Hindustan Institute of Technology and Science, Chennai, and Saveetha Medical College and Hospital, Saveetha Institute of Medical and Technical Sciences (SIMATS) Thandalam for their support and guidance throughout this study.
CONFLICT OF INTEREST
The authors declare that there is no conflict of interest.
AUTHORS’ CONTRIBUTION
SM conceptualized the study. SM collected resources. MV performed data collection. SM and MV applied methodology. SI performed visualization and project administration. PS performed formal analysis and investigation. SS performed acquisition, supervision and data validation. SM wrote the original draft. PS and SS reviewed and edited the manuscript. MV wrote the manuscript. All authors read and approved the final manuscript for publication.
FUNDING
None.
DATA AVAILABILITY
All datasets generated or analyzed during this study are included in the manuscript.
ETHICS STATEMENT
Not applicable.
- Ncube LK, Ude AU, Ogunmuyiwa EN, Zulkifli R, Beas IN. An overview of plastic waste generation and management in food packaging industries. Recycling. 2021;6(1):12.
Crossref - Thompson RC, Swan SH, Moore CJ, Vom Saal FS. Our plastic age. Philos Trans Royal Society B: Biol Sci. 2009;364(1526):1973-1976.
Crossref - Sid S, Mor RS, Kishore A, Sharanagat VS. Bio-sourced polymers as alternatives to conventional food packaging materials: A review. Trends Food Sci Technol. 2021;115:87-104.
Crossref - Lackner M, Mukherjee A, Koller M. What are “bioplastics”? Defining renewability, biosynthesis, biodegradability, and biocompatibility. Polymers. 2023;15(24):4695.
Crossref - Yu Y, Griffin-LaHue DE, Miles CA, Hayes DG, Flury M. Are micro-and nanoplastics from soil-biodegradable plastic mulches an environmental concern? J Hazard Mater Adv. 2021;4:100024.
Crossref - Janani R, Bhuvana S, Geethalakshmi V, et al. Micro and nano plastics in food: A review on the strategies for identification, isolation, and mitigation through photocatalysis, and health risk assessment. Environ Res. 2024;241:117666.
Crossref - Yaashikaa PR, Kamalesh R, Kumar PS, Saravanan A, Vijayasri K, Rangasamy G. Recent advances in edible coatings and their application in food packaging. Food Res Int. 2023;173(pt 2):113366.
Crossref - Chan-Matu DI, Toledo-Lopez VM, Vargas MD, Rincon-Arriaga S, Rodriguez-Felix A, Madera-Santana TJ. Preparation and characterization of chitosan-based bioactive films incorporating Moringa oleifera leaves extract. J Food Meas Charact. 2021;15(5):4813-4824.
Crossref - Adilah AN, Jamilah B, Noranizan MA, Nur Hanani ZA. Utilization of mango peel extracts on the biodegradable films for active packaging. Food Packag Shelf Life. 2018;16:1-7.
Crossref - Hasan M, Zafar A, Shahzadi I, et al. Fractionation of biomolecules in Withania coagulans extract for bioreductive nanoparticle synthesis, antifungal and biofilm activity. Molecules. 2020;25(15):3478.
Crossref - Grujic R, Vujadinovic D, Savanovic D. Biopolymers as Food Packaging Materials. In: Pellicer, E., et al. Advances in Applications of Industrial Biomaterials. Springer, Cham. 2017:139-60.
Crossref - Adeyeye OA, Sadiku ER, Reddy AB, et al. The Use of Biopolymers in Food Packaging. In: Gnanasekaran, D. (eds) Green Biopolymers and their Nanocomposites. Materials Horizons: From Nature to Nanomaterials. Springer, Singapore. 2019:137-158.
Crossref - Kaur D, Yousuf B, Qadri OS. Syzygium cumini anthocyanins: recent advances in biological activities, extraction, stability, characterisation, and utilisation in food systems. Food Prod Process and Nutr. 2024;6(1):34.
Crossref - Santhosh R, Sarkar P. Fabrication of jamun seed starch/tamarind kernel xyloglucan bio-nanocomposite films incorporated with chitosan nanoparticles and their application on sapota (Manilkara zapota) fruits. Int J Biol Macromol. 2024;260(Pt 2):129625.
Crossref - Coban B, Bilgin B, Yurt B, Kopuk B, Atik DS, Palabiyik I. Utilization of the barberry extract in the confectionery products. LWT. 2021;145:111362.
Crossref - Parida M, Shajkumar A, Mohanty S, Biswal M, Nayak SK. Poly (lactic acid)(PLA)-based mulch films: evaluation of mechanical, thermal, barrier properties and aerobic biodegradation characteristics in a real-time environment. Polymer Bulletin. 2023;80(4):3649-3674.
Crossref - Moraczewski K, Pawłowska A, Stepczyńska M, et al. Plant extracts as natural additives for environmentally friendly polylactide films. Food Packaging and Shelf Life. 2020;26:100593.
Crossref - Casagrande M, Zanela J, Wagner Junior A, et al. Optical, Mechanical, Antioxidant and Antimicrobial Properties of Starch/Polyvinyl Alcohol Biodegradable Film Incorporated with Baccharis dracunculifolia Lyophilized Extract. Waste Biomass Valor. 2021;12(7):3829-3848.
Crossref - Debiagi F, Kobayashi RK, Nakazato G, Panagio LA, Mali S. Biodegradable active packaging based on cassava bagasse, polyvinyl alcohol, and essential oils. Industrial Crops and Products. 2014;52:664-670.
Crossref - Vanaraj R, Kumar SMS, Mayakrishnan G, Rathinam B, Kim SC. A current trend in efficient biopolymer coatings for edible fruits to enhance shelf life. Polymers. 2024 ;16(18):2639.
Crossref - Abdin M, El-Beltagy AE, El-Sayed ME, Naeem MA. Production and characterization of sodium alginate/Gum Arabic based films enriched with Syzygium cumini seeds extracts for food application. J Polym Environ. 2022;30(4):1615-1626.
Crossref - Musa BH, Hameed NJ. Effect of crosslinking agent (glutaraldehyde) on the mechanical properties of (PVA/Starch) blend and (PVA/PEG) binary blend films. J Phys Conf Ser. 2021;1795(1):012064.
Crossref - Gidado MJ, Gunny AAN, Gopinath SCB, Ali A, Wongs-Aree C, Salleh NHM. Challenges of postharvest water loss in fruits: Mechanisms, influencing factors, and effective control strategies – A comprehensive review. J Agric Food Res. 2024;17:101249.
Crossref - Pobiega K, Przybyl JL, Zubernik J, Gniewosz M. Prolonging the shelf life of cherry tomatoes by pullulan coating with ethanol extract of propolis during refrigerated storage. Food Bioprocess Technol. 2020;13(8):1447-1461.
Crossref - Kumar N, Kaur P, Devgan K, Attkan AK. Shelf life prolongation of cherry tomato using magnesium hydroxide reinforced bio nanocomposite and conventional plastic films. J Food Process Preservation. 2020;44(4):e14379.
Crossref - Qiao J, Wang L, Wang L, Li Z, Huai Y, Zhang S, Yu Y. Development and characterization of modified gelatin-based cling films with antimicrobial and antioxidant activities and their application in the preservation of cherry tomatoes. Antioxidants. 2024;13(4):431.
Crossref - Das G, Nath R, Talukdar AD, et al. Major bioactive compounds from Java plum seeds: An investigation of its extraction procedures and clinical effects. Plants. 2023;12(6):1214.
Crossref - Kaur N, Aggarwal P. Development and characterisation of packing, microstructural, physico- and phytochemical attributes of potential functional jamun (Syzygium cumini L.) pomace powder for direct compression: high antioxidant nutraceutical tablets. Int J Food Sci Technol. 2022;58(4):2067-2076.
Crossref - Parimala SM, Salomi AA. GC-MS analysis and antimicrobial assessment of Syzygium cumini (L.) skeels seed ethanol extract. J Pharm Res Intl. 2021;33(56B):271-83.
Crossref - Yang D, Fan B, Sun G, He YC, Ma C. Ultraviolet blocking ability, antioxidant and antibacterial properties of newly prepared polyvinyl alcohol-nanocellulose silver nanoparticles-ChunJian peel extract composite film. Int J Biol Macromol. 2023;252:126427.
Crossref - CLSI. Performance Standards for Antimicrobial Susceptibility Testing. 26th ed. CLSI supplement M100S. Wayne, PA: Clinical and Laboratory Standards Institute;2016.
- Gomathi D, Kalaiselvi M, Ravikumar G, Devaki K, Uma C. GC-MS analysis of bioactive compounds from the whole plant ethanolic extract of Evolvulus alsinoides (L.) L. J Food Sci Technol. 2015;52(2):1212-1217.
Crossref - Bari T, Saeed S, Tayyab M, Anjum AA, Mehmood T. GC-MS bioactives profiling, antibacterial and cytotoxic potential of Jamun (Syzygium cumini L.) extracts against food-Borne pathogen Salmonella enteritidis. Pharm Chem J. 2024;57(10):1586-92.
Crossref - Sajjan AM, Naik ML, Kulkarni AS, et al. Preparation and characterization of PVA-Ge/PEG-400 biodegradable plastic blend films for packaging applications. Chemical Data Collections. 2020;26:100338.
Crossref - Kumar D, Kumar P, Pandey J. Binary grafted chitosan film: Synthesis, characterization, antibacterial activity, and prospects for food packaging. Int J Biol Macromol. 2018;115:341-348.
Crossref - Vilca JAC, Ortiz-Quispe BS, Apaza-Cusiatau CR, et al. Evaluation of the barrier and antimicrobial properties of biodegradable films based on potato waste starch containing natural additives. SN Appl Sci. 2023;5(12).
Crossref - Mousavi Z, Babaei S, Naseri M, Hosseini SMH, Shekarforoush SS. Utilization in situ of biodegradable films produced with chitosan, and functionalized with ε-poly-l-lysine: an effective approach for super antibacterial application. Food Measure. 2022;16(2):1416-1425.
Crossref - Sofla MSK, Mortazavi S, Seyfi J. Preparation and characterization of polyvinyl alcohol/chitosan blends plasticized and compatibilized by glycerol/polyethylene glycol. Carbohydrate Polymers. 2019;232:115784.
Crossref - Falqi FH, Bin-Dahman OA, Hussain M, Al-Harthi MA. Preparation of miscible PVA/PEG blends and effect of graphene concentration on thermal, crystallization, morphological, and mechanical properties of PVA/PEG (10 wt%) blend. Int J Polym Sci. 2018;2018(1):8527693.
Crossref - Bukhary SKHS, Choudhary FK, Iqbal DN, et al. Development and characterization of a biodegradable film based on guar gum-gelatin@sodium alginate for a sustainable environment. RSC Adv. 2024;14(27):19349-19361.
Crossref - Tak Y, Kaur M, Jain MC, et al. Jamun seed: A review on bioactive constituents, nutritional value and health benefits. Polish J Food Nutr Sci. 2022;72(3):211-228.
Crossref - Riano AMS, Vivas EMA, Andrade HPB, et al. Physicochemical, structural, and thermal characterization of biodegradable film prepared using arracacha thermoplastic starch and polylactic acid. Food Measure. 2022;16(5):3597-606.
Crossref - Nasution H, Harahap H, Julianti E, Safitri A, Jaafar M. Properties of active packaging of PLA-PCL film integrated with chitosan as an antibacterial agent and Syzygium cumini seed extract as an antioxidant agent. Heliyon. 2024;10(1):e23952.
Crossref - Yadav AK, Saraswat S, Sirohi P, et al. Antimicrobial action of methanolic seed extracts of Syzygium cumini Linn. on Bacillus subtilis. AMB Expr. 2017;7(1):196.
Crossref - Das A, Bharath M, Jeevanantham M, Kumar SM, Bindhu RPTJ. Phytochemical screening and antimicrobial activity of Syzygium cumini (Jamun) seed extract. Res J Pharm Technol. 2018;11(9):4096-4100.
Crossref - Sudha K, Mathanghi SK, Nirmal RM. GC-MS analysis of bioactive components in Jamun, Amla, and Kiwi fruits. Pharma Innovation Journal. 2023:12(6):892-899
- Parimala SM, Salomi AA. GC-MS analysis and antimicrobial assessment of Syzygium cumini (L.) skeels seed ethanol extract. J. Pharm. Res. Intl. 2021; 33:271-283.
Crossref - Abdul Jaleel AH, Mahdi jF, Farooqui M, Shaikh YH. Gas Chromatography-mass spectroscopic analysis of black plum seed (Syzygium cumini) extract in hexane. Asian J Pharm Clin Res. 2019;12(2):219-222.
Crossref - Thiagamani SMK, Yaswanth CV, Yashwanth C, Tran TMN, Krishnasamy S, Azhaguchamy M, Khan A, Hashem M, Fouad H. Characterization of Syzygium cumini (L.) Skeels (Jamun Seed) Particulate Fillers for Their Potential Use in Polymer Composites. Molecules. 2024; 29(11):2618.
Crossref - Gholami A, Pourmadadi M, Abdouss H, et al. Formulation of double microemulsion based on pH-responsive PEG/PVA/zinc oxide as a potential nano-platform for drug delivery: Green synthesis, and physico-chemical characterization. J Mol Liq. 2024;410:125563.
Crossref - Sridhar N, Vallavi MSA, Mugilan T. Synthesis and characterization of polyvinyl alcohol/Senna alata extract incorporated film for biomedical application. Polym Bull. 2024;81(15):13839-13862.
Crossref - Gulati K, Lal S, Arora S. Synthesis and characterization of PVA/Starch/CMC composite films reinforced with walnut (Juglans regia L.) shell flour. SN Appl Sci. 2019;1(11):1416.
Crossref - Liu Q, Stuart T, Hughes M, Sharma HS, Lyons G. Structural bio composites from flax–Part II: The use of PEG and PVA as interfacial compatibilising agents. Compos Part A Appl Sci Manuf. 2007;38(5):1403-1413.
Crossref - Devangamath SS, Lobo B, Masti SP, Narasagoudr S. Thermal, mechanical, and AC electrical studies of PVA–PEG–Ag2S polymer hybrid material. J Mater Sci Mater Electron. 2020;31(4):2904-2917.
Crossref - Weligama Thuppahige VT, Moghaddam L, Welsh ZG, Karim A. Investigation of morphological, chemical, and thermal properties of biodegradable food packaging films synthesised by direct utilisation of cassava (Monihot esculanta) Bagasse. Polymers. 2023;15(3):767.
Crossref - Bashir A, Jabeen S, Gull N, et al. Co-concentration effect of silane with natural extract on biodegradable polymeric films for food packaging. Int J Biol Macromol. 2018;106:351-359.
Crossref - Kola V, Carvalho IS. Plant extracts as additives in biodegradable films and coatings in active food packaging. Food Biosci. 2023;54:102860.
Crossref - Kaya M, Ravikumar P, Ilk S, et al. Production and characterization of chitosan based edible films from Berberis crataegina’s fruit extract and seed oil. Innov Food Sci Emerg Technol. 2018;45:287-97.
Crossref - Riaz A, Lagnika C, Luo H, et al. Chitosan-based biodegradable active food packaging film containing Chinese chive (Allium tuberosum) root extract for food application. Int J Biol Macromol. 2020;150:595-604.
Crossref - Giacondino C, De Bruno A, Puntorieri D, Pizzimenti M, Piscopo A. Impact of antioxidant-enriched edible gel coatings and bio-based packaging on cherry tomato preservation. Gels. 2024;10(9):549.
Crossref - Annu, Ali A, Ahmed S. Eco-friendly natural extract loaded antioxidative chitosan/polyvinyl alcohol based active films for food packaging. Heliyon. 2021;7(3):e06550.
Crossref - Salih HM, Amachawadi RG, Kang Q, Li Y, Nagaraja TG. In Vitro Antimicrobial Activities of Grape Seed, Green Tea, and Rosemary Phenolic Extracts Against Liver Abscess Causing Bacterial Pathogens in Cattle. Microorganisms. 2024;12(11):2291.
Crossref - Ghazi S. Do the polyphenolic compounds from natural products can protect the skin from ultraviolet rays? Results in Chemistry. 2022;4:100428.
Crossref - Trivedi B, Singh P. Screening of Antibacterial Activity of Syzygium Jambolanum (Jamun) Seed Extract. Int J Basic Appl Biol. 2015;2:237-240.
- Jagetia GC. Phytochemical Composition and pleotropic pharmacological properties of jamun, Syzygium cumini Skeels. J Explor Res Pharmacol. 2017;2(2):54-66.
Crossref - Chandrasekaran M, Venkatesalu V. Antibacterial and antifungal activity of Syzygium jambolanum seeds. J Ethnopharmacol. 2004;91(1):105-108.
Crossref - Kumar M, Hasan M, Lorenzo JM, et al. Jamun (Syzygium cumini (L.) Skeels) seed bioactives and its biological activities: A review. Food Biosci. 2022;50:102109.
Crossref - Perera KY, Sharma S, Duffy B, Pathania S, Jaiswal AK, Jaiswal S. An active biodegradable layer-by-layer film based on chitosan-alginate-TiO2 for the enhanced shelf life of tomatoes. Food Packag Shelf Life. 2022;34:100971.
Crossref - Zhao Z, Xu Y, Zou P, Xu L, Cai J. Developing a pachyman/polyvinyl alcohol-polylactic acid bilayer film as multifunctional packaging and its application in cherry tomato preservation. LWT. 2023;186:115249.115249.
Crossref - Song W, Li Z, Qu J, et al. Multifunctional composite polyvinyl alcohol film reinforced with polymeric ionic liquid-modified cellulose nanocrystals for multimodal bacteriostatic food packaging. Int J Biol Macromol. 2025;317:144852.
Crossref
© The Author(s) 2026. Open Access. This article is distributed under the terms of the Creative Commons Attribution 4.0 International License which permits unrestricted use, sharing, distribution, and reproduction in any medium, provided you give appropriate credit to the original author(s) and the source, provide a link to the Creative Commons license, and indicate if changes were made.